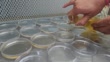

A close-up of laboratory technician pouring E. coli bacteria into petri dishes in research lab - HD stock video
A close-up of laboratory technician pouring E. coli bacteria into petri dishes in research lab

PURCHASE A LICENSE
All Royalty-Free licenses include global use rights, comprehensive protection, simple pricing with volume discounts available
€475.00
EUR
DETAILS
Credit:
51³Ô¹ÏÍø #:
1679983687
License type:
Collection:
Creatas Video
Max file size:
1920 x 1080 px - 15 MB
Clip length:
00:00:11:16
Upload date:
Location:
India
Release info:
No release required
Mastered to:
QuickTime 8-bit H.264 HD 1920x1080 25p
Categories:
- Analyzing,
- Antibiotic,
- Bacterial Mat,
- Bacterium,
- Biology,
- Biotechnology,
- Circle,
- Close-up,
- Colony - Group of Animals,
- E. coli,
- Endocarditis,
- Examining,
- Film - Moving Image,
- Fungal Disease,
- Fungal Mold,
- Fungal Pathogen,
- Fungus,
- Gelatin,
- Glass - Material,
- HD Format,
- Healthcare And Medicine,
- Horizontal,
- Incubator,
- India,
- Laboratory,
- Laboratory Equipment,
- Medical Research,
- Microbiology,
- Mycobacterium,
- Non US Film Location,
- Petri Dish,
- Planting,
- Plasmid,
- Plate,
- Real Time Video,
- Research,
- Science,
- Scientific Experiment,
- Scientific Sample,
- Working,